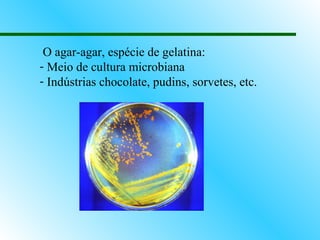
O agar-agar, espécie de gelatina:
- Meio de cultura microbiana
- Indústrias chocolate, pudins, sorvetes, etc.

O documento descreve os principais grupos de protozoários e algas, incluindo suas características, exemplos e importância. Os protozoários são classificados de acordo com sua estrutura locomotora e incluem sarcodíneos, flagelados, ciliados e esporozoários. Algas são divididas em verdes, vermelhas e pardas, sendo importantes fontes de alimentos e produtos industriais como agar-agar.